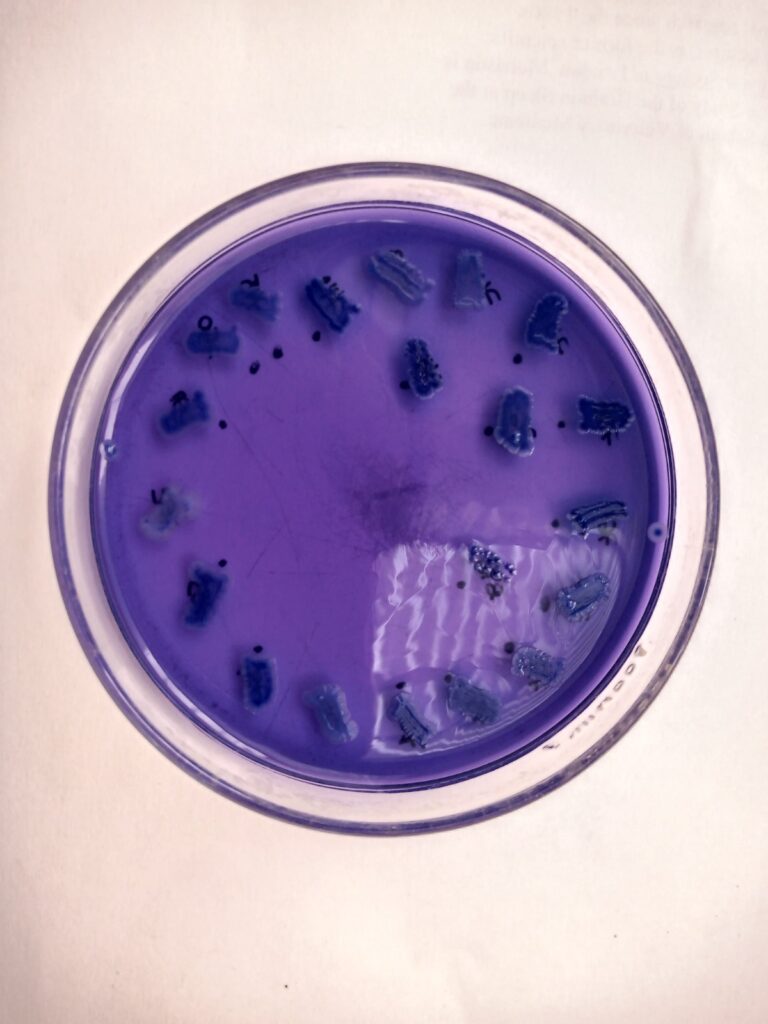

Un trabajo de tesis realizado por una estudiante de la Universidad Nacional de la Patagonia San Juan Bosco evaluó la presencia de enterococos en aves silvestres y de cría en el Valle Inferior del Río Chubut y Península Valdés, así como su resistencia a metales pesados y antimicrobianos.
Con el apoyo del Gobierno del Chubut, a través de la Secretaría de Ciencia y Tecnología, una estudiante de la Universidad Nacional de la Patagonia San Juan Bosco (UNPSJB) analizó la presencia de bacterias resistentes a metales pesados y antibióticos en aves del Valle Inferior del Río Chubut y Península Valdés.
El estudio, financiado por el organismo provincial a través del Programa de Apoyo Económico a Tesis y Proyectos Finales, fue desarrollado por Débora Andoro en el marco del Seminario de Licenciatura en Ciencias Biológicas realizado en el Laboratorio de Biotecnología Bacteriana de la Facultad de Ciencias Naturales y Ciencias de la Salud de la UNPSJB, sede Trelew.
Investigación
El objetivo principal fue evaluar la presencia de enterococos en aves silvestres y de cría de la comarca del Valle Inferior del Río Chubut y Península Valdés, y estudiar su resistencia a metales pesados y antimicrobianos. Estos microorganismos se consideran indicadores eficaces debido a su alta resistencia a condiciones adversas como salinidad, temperatura y desinfectantes, lo que les permite permanecer más tiempo en el ambiente.
Las bacterias fueron aisladas de muestras de heces frescas y analizadas mediante técnicas fenotípicas y genotípicas. Entre los resultados, no se observó resistencia frente a cadmio y mercurio, pero sí contra níquel, cobre, zinc, cromo y plomo. En cuanto a los antibióticos, la vancomicina y la gentamicina resultaron ser los más efectivos, mientras que la mayor resistencia se detectó frente a la ampicilina, seguida por la estreptomicina y la tetraciclina.
La resistencia a antimicrobianos es reconocida por la Organización Mundial de la Salud como una de las diez principales amenazas para la salud pública mundial. En ese contexto, los resultados obtenidos alertan sobre el papel de las aves –tanto silvestres como de cría– como reservorios de bacterias resistentes, lo que podría facilitar su propagación en ambientes urbanos y rurales, con implicancias para la salud humana, animal y ambiental.
Financiamiento
Este proyecto, titulado “Las aves como indicadores biológicos de contaminación ambiental: aislamiento de Enterococcus spp. resistentes a metales pesados”, contó con el apoyo de la Secretaría de Ciencia y Tecnología del Chubut, mediante el Programa de Apoyo Económico a Tesis y Proyectos Finales (Res. SCTIPyC N°79/2021).
Dicha iniciativa busca fortalecer la formación de estudiantes avanzados de universidades con sede en la provincia, brindando financiamiento para investigaciones con impacto local y regional.
Los interesados pueden acceder al artículo completo en el siguiente link:
https://www.revistas.una.ac.cr/index.php/ambientales/article/view/20218